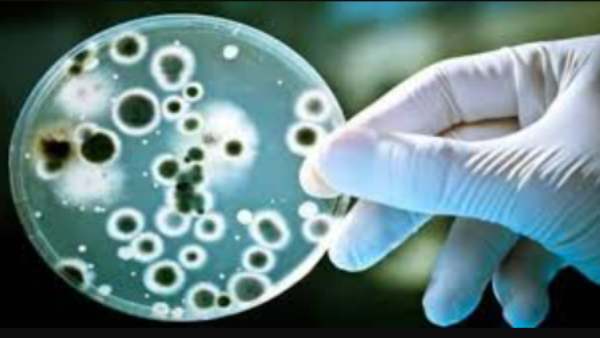
கடைபிடியுங்கள்

காலரா நோய்: எதையெல்லாம் செய்யலாம்.. எதை செய்யக் கூடாது.. டாக்டர் பரூக் அப்துல்லா விளக்கம்
சிவகங்கை: காலராவை தடுக்க என்னென்ன செய்ய வேண்டும் என்பதை விளக்கியுள்ளார் அரசு மருத்துவர் டாக்டர் பரூக் அப்துல்லா.
Recommended Video
இதுகுறித்து சிவகங்கை அரசு பொது மருத்துவர் டாக்டர் பரூக் அப்துல்லா தனது பேஸ்புக் பதிவில் கூறியிருப்பதாவது: புதுச்சேரி காரைக்கால் மாவட்டத்தில் காலரா மற்றும் வயிற்றுப் போக்கு கொள்ளை நோயாக உருவெடுத்துள்ளது. இந்நிலையில் புதுச்சேரி யூனியன் பிரதேச சுகாதார மற்றும் குடும்ப நலத்துறை காரைக்கால் மாவட்டத்தில் "பொது சுகாதார அவசர நிலையை" பிரகடனப்படுத்தியுள்ளது.
கடந்த இரண்டு வாரங்களில் மட்டும் சுமார் 1600 பேருக்கு வயிற்றுப்போக்கு ஏற்பட்டுள்ளது. அதில் சுமார் 700 பேர் மருத்துவமனைகளிலும் ஆரம்ப சுகாதார நிலையங்களிலும் தங்கி சத்திர சிகிச்சை பெற்றுள்ளனர் என்றும் 17 பேருக்கு காலரா தொற்று இருந்ததும் கண்டறியப்பட்டுள்ளது.

மாவட்டத்தினர் என்ன செய்ய வேண்டும்?
புதுச்சேரியில் இருந்து சுகாதாரத் துறை அலுவலர்கள் காரைக்கால் விரைந்து வந்து பல்வேறு அரசு துறையினரின் ஒத்துழைப்புடன் தொற்றுப் பரவலை கட்டுக்குள் வைக்கும் பணியில் ஈடுபட்டுள்ளனர். இந்நிலையில் காரைக்கால் மாவட்ட மக்கள் செய்ய வேண்டியவை பின்வருமாறு:
1. குடிக்கும் நீரை 20 நிமிடங்கள் கொதிக்க வைத்துப் பருக வேண்டும்
2. பொது இடங்களிலும் ஹோட்டல்களிலும் பாதுகாப்பான சுத்தமான தண்ணீரை பருகுவதை உறுதி செய்ய வேண்டும்
3. வீட்டிலோ அல்லது சுற்றத்திலோ யாருக்கேனும் வயிற்றுப்போக்கு ஏற்படின் தன் சுத்தம் பேணும் நடவடிக்கைகளை துரிதப்படுத்த வேண்டும். குறிப்பாக அடிக்கடி கைகளை சோப் போட்டுக் கழுவ வேண்டும்.
4. உண்ணும் உணவுகளை சமைப்பதற்கு முன் நன்றாக கழுவியும் முறையாக சமைத்தும் உண்ண வேண்டும்

கழிப்பறைகள்
5. பொதுவெளியில் மலம் கழிப்பதை கட்டாயம் தவிர்க்க வேண்டும் . எப்போதும் கழிப்பறைகளை உபயோகிக்க வேண்டும்.
6. வாந்தி, வயிற்றுப்போக்கு, காய்ச்சல் போன்ற அறிகுறிகள் தோன்றினால் உடனே அருகில் உள்ள அரசு ஆரம்ப சுகாதார நிலையங்கள் /மருத்துவமனைகளை உடனே அணுகிட வேண்டும்.
7. ஓ.ஆர். எஸ் திரவத்தின் ( ORAL REHYDRATION SALT SOLUTION) முக்கியத்துவத்தை உணர்ந்து வயிற்றுப்போக்கு ஏற்படுபவர்களுக்கு ஒரு லிட்டர் காய்ச்சி வடிகட்டிய தண்ணீரில் ஓ.ஆர்.எஸ் பொடியைக் கலந்து கொடுத்து வர வயிற்றுப்போக்கின் தீவிரம் வெகுவாகக் குறையும்.

மருத்துவ உதவி
8. தங்களது உறவினர்கள் மற்றும் சுற்றத்தில் வயிற்றுப்போக்கு பாதிப்பு யாருக்கேனும் ஏற்பட்டிருந்தால் குறிப்பாக முதியவர்களுக்கு தொற்று இருந்தால் அவர்களுக்கு மருத்துவ உதவி கிடைக்க உடனே ஏற்பாடு செய்வது சிறந்தது.
9. வீடுகளுக்கு வரும் குடிநீர் குழாய்களில் எங்கேனும் விரிசல் ஏற்பட்டு ஒழுகிக் கொண்டிருந்தால் உடனே சம்பந்தப்பட்ட அதிகாரிகளுக்குத் தெரியப்படுத்திட வேண்டும்.
10. வயிற்றுப்போக்குக்கும் வாந்திக்கும் மருத்துவப் பரிந்துரையின்றி மருந்தகங்களில் சுயமருத்துவம் செய்து பொன்னான நேரத்தைக் கடத்துவது ஆபத்தான காரியமாகும்.
கடைபிடியுங்கள்
மேற்சொன்ன விஷயங்களை பொதுமக்கள் கடைபிடித்து இந்த கொள்ளை நோயின் தீவிரத்தை மட்டுப்படுத்தி உயிரிழப்புகள் ஏற்படாத வண்ணம் இதில் இருந்து வெளியேற உதவிகரமாக இருக்கும். வயிற்றுப்போக்கு ஏற்பட்டால் உடனடியாக அரசு மருத்துவமனைகளை அணுகிடுவது பல உயிர்களைக் காக்கும் செயலாகும்.

காரைக்கால் மட்டும் அல்ல
காரைக்கால் மற்றும் அதன் அண்டை மாவட்டங்கள் சுதாரிப்புடன் இருந்து இந்த கொள்ளை நோய் தொற்றுப் பரவலில் இருந்து விரைவில் மீண்டு வர பிரார்த்தனைகள் மேற்சொன்ன விசயங்கள் காரைக்காலுக்கு மட்டுமன்றி அனைவருக்குமே தேவையான ஒன்றாகும். எனவே அனைவரும் கடைபிடித்து நமது ஊர்களில் தொற்றுப் பரவல் நிகழாமல் கவனித்துக் கொள்ளலாம் என மருத்துவர் பரூக் அப்துல்லா தெரிவித்துள்ளார்.
-
திருச்சி கிழக்கு இடைத்தேர்தல்.. தவெக வேட்பாளராக சிரஞ்சீவி? மேடையில் முதல்வர் விஜய் தந்த செம ஹிண்ட் -
நன்றி மறக்காத விஜய்.. தவெகவின் முதல் ராஜ்யசபா எம்பி யார்? ரேசில் முன்னணியில் ’லெஃப்ட் - ரைட்’ ஹேண்ட் -
“தவெகவுக்கு ஓட்டு போடாத தென்காசி மக்களும் பாதிக்கப்படுகிறோம்”.. நள்ளிரவில் எழுந்த திடீர் போராட்டம்! -
"பச்சை துரோகம்.. வாக்கு அறுவடை முடிந்ததும் ரிசர்வ் வங்கியை காரணம் காட்டுவதா?" தங்கம் தென்னரசு தாக்கு -
திமுகவிற்கு விஜய் சொன்ன 'நோ'.. ஸ்விட்ச் ஆப் ஆன போன்.. மேஜைக்கு வந்த உளவுத்துறை ரிப்போர்ட்! -
SP Velumani: வேலுமணிக்கு வில்லனாக மாறிய முனுசாமி.. பதவிக்கு விழுந்த வேட்டு! -
கொ*யில் முடிந்த பார் டான்ஸ்.. கொதித்துப் போன கோயம்பேடு! யான்சிக்கு இப்படியா சாவு வரனும்! ஷாக்! -
Annamalai New Party LIVE:தனிக் கட்சி தொடங்குகிறார் அண்ணாமலை? பிறந்தநாளன்று வெளியாகும் அப்டேட்? -
விஜய்க்கு பெரிய தலைவலி.. ஒரே நாளில் வீட்டுக்கு போன 5000 ஊழியர்கள் ஓய்வு! ஆட்டம் காணும் அரசு துறைகள் -
நான் பார்த்துகிறேன் நண்பா.. உறுதியாக சொன்ன விஜய்.. அஜித் தாய் மறைந்த இரவு.. நடந்தது என்ன? -
பிளாக் அண்ட் ஒயிட் கோட் சூட் அணிவது இதற்காகத் தான்.. ரகசியத்தை போட்டு உடைத்த விஜய்! -
காலியான ராஜ்யசபா எம்பி பதவி! இன்று வேட்புமனு தாக்கல் தொடக்கம்! தவெகவின் முதல் எம்பி யார்?












Click it and Unblock the Notifications